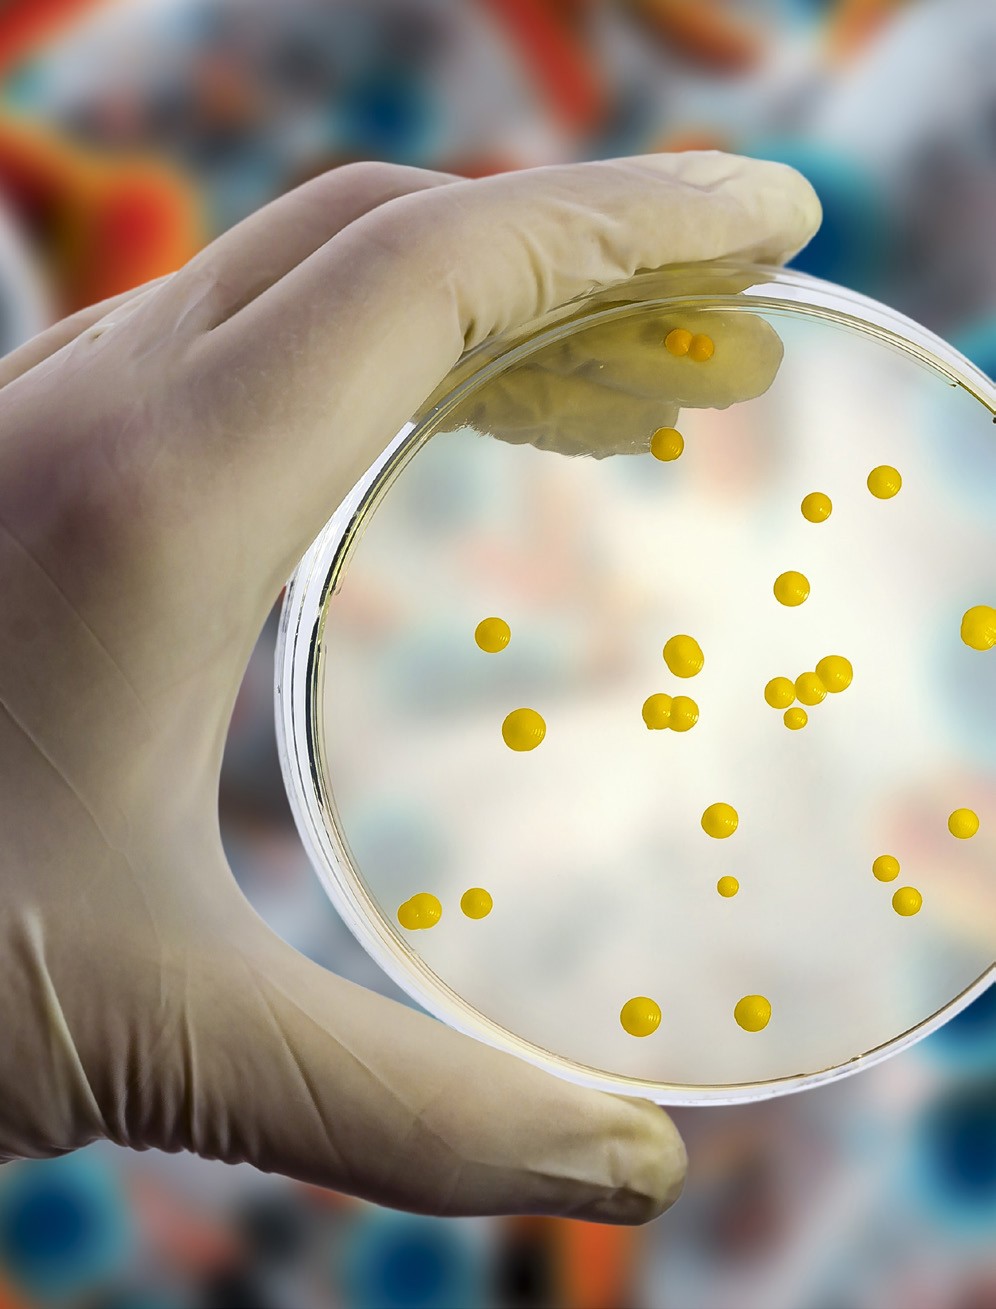
FDA grants IND clearance to Spero Therapeutics’ bacterial infection ...

Explore the educational aspects of fda grants ind approval to base therapeutics' base-edited nk cell through extensive collections of informative visual resources. enhancing knowledge retention through engaging and informative imagery. encouraging critical thinking and analytical skill development. Discover high-resolution fda grants ind approval to base therapeutics' base-edited nk cell images optimized for various applications. Excellent for educational materials, academic research, teaching resources, and learning activities All fda grants ind approval to base therapeutics' base-edited nk cell images are available in high resolution with professional-grade quality, optimized for both digital and print applications, and include comprehensive metadata for easy organization and usage. Educators appreciate the pedagogical value of our carefully selected fda grants ind approval to base therapeutics' base-edited nk cell photographs. Professional licensing options accommodate both commercial and educational usage requirements. Cost-effective licensing makes professional fda grants ind approval to base therapeutics' base-edited nk cell photography accessible to all budgets. Reliable customer support ensures smooth experience throughout the fda grants ind approval to base therapeutics' base-edited nk cell selection process. Each image in our fda grants ind approval to base therapeutics' base-edited nk cell gallery undergoes rigorous quality assessment before inclusion. Advanced search capabilities make finding the perfect fda grants ind approval to base therapeutics' base-edited nk cell image effortless and efficient.